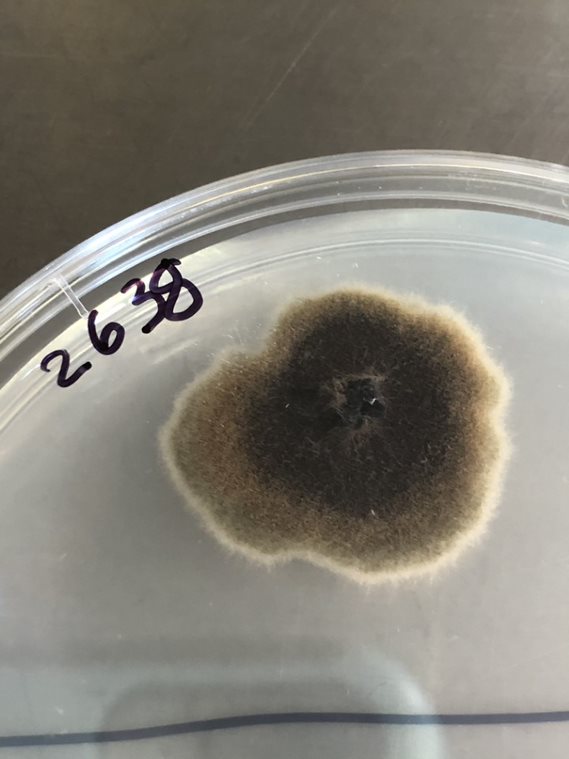
MicroMGx tweet media
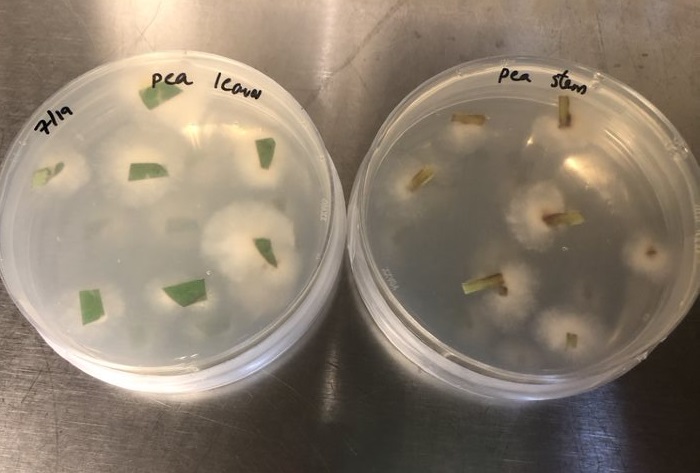
MicroMGx tweet media

See you in Paris!
Hello Tomorrow@hellotmrc
For the 8th consecutive edition, we’re announcing our yearly @hellotmrc Global Challenge finalists. An international jury of experts carefully reviewed over 4000 applications and identified 70 projects that stood out👏🌎 Discover our finalists here 👉hello-tomorrow.org/the-70-finalis…
English